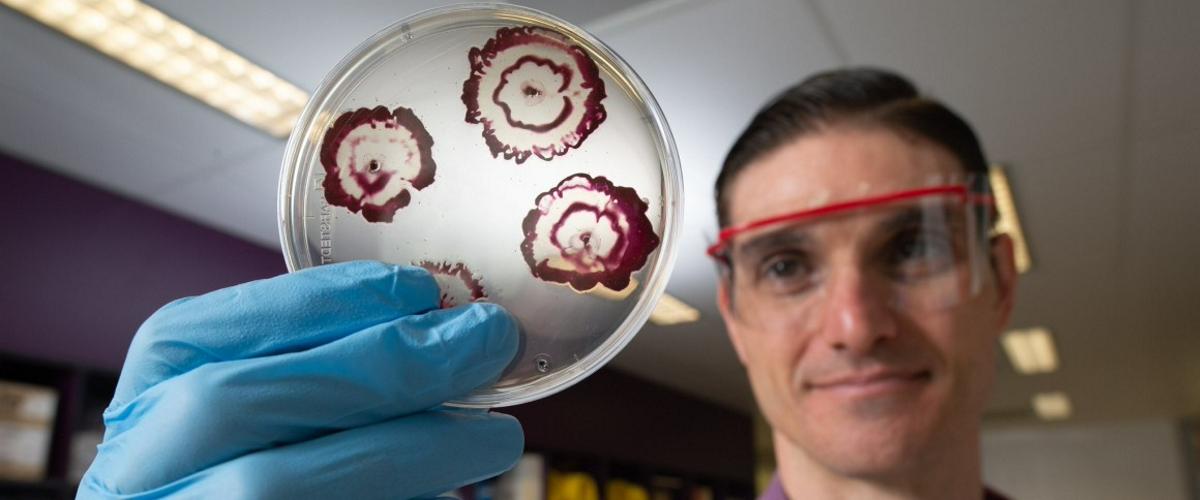
TODO:

Многие болезнетворные бактерии умеют образовывать биопленки, непроницаемые для антибиотиков. Эта проблема особенно актуальна для вживляемых медицинских устройств, например, катетеров и различных имплантов. Бактериальные биопленки могут не только затруднить лечение, но и стать источником антибиотик-резистентных штаммов.
Исследователи из Квинслендского технологического университета, о работе которых рассказывает New Atlas, нашли способ разрушить эту защиту. Чтобы разрушить биопленки, они соединили популярный антибиотик ципрофлоксацин с веществами, известными как нитроксиды.
Механизм действия гибридного препарата прост: нитроксиды создают разрыв в защитной оболочке пленки, позволяя ципрофлоксацину проникнуть внутрь и атаковать бактерии.
Эксперименты с биопленками золотистого стафилококка продемонстрировали эффективность нового подхода. Что особенно важно, для достижения результата потребовалось меньше ципрофлоксацина, чем обычно. Исследователи не выявили никаких признаков токсичности для человеческих клеток.
То, что в работе использовались уже одобренные препараты, означает, что уже в ближайшее время команда сможет приступить к испытаниям на людях.
Болезнетворные бактерии нередко переходят от одного вида-хозяина к другому. Исследователи из Великобритании выяснили, как им это удается.